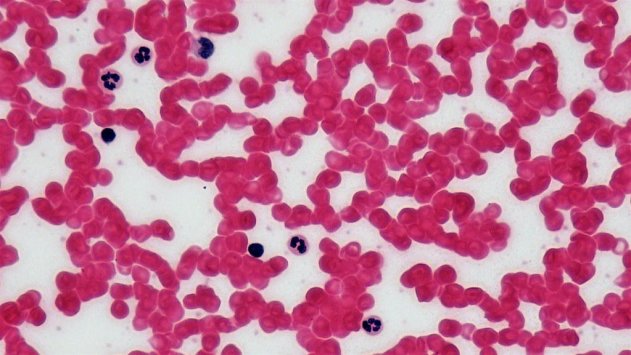

Подводные «нано-лодки» вылечат человека от рака - «Наука»
- 16:01, 31-май-2019
- Наука
- Ogden
- 0
Роботы не смогут найти очаг рака, если человек во время процедуры будет сидеть.
На днях, инженеры из Университета Нового Южного Уэльса продемонстрировали микро-роботов, работающих на нано-моторах и способных выполнять роль почтальона в организме человека. Они обеспечивают пооставку препаратов напрямую к больным органам, без какого-либо внешнего воздействия. Учёные уверены, что разработанные ими подводные «нано-лодки» вылечат в будущем человека от рака.
Рассказывая о своём открытие в Сиднее, разработчики поделились подробностями своего открытия. По их словам, роботы были изготовлены в нано-размере. Это необходимо для их дальнейшего использования в биологической среде, где они будут плавать.
Говоря о «нано-лодках» автор исследования и доктор Кан Лян сказал, что данная конструкция не нуждается в манипуляциях со стороны, которые прежде использовались с целью поиска проблемной области тела. Такой факт делает открытие уникальным. В ходе тестирования инженеры продемонстрировали, как микро-роботы используют кислород или воду для заполнения балластных точек, за счёт чего становятся плавучими. Также важно положение больного, которое должно быть строго вертикальным или лежачим.

Комментарии (0)